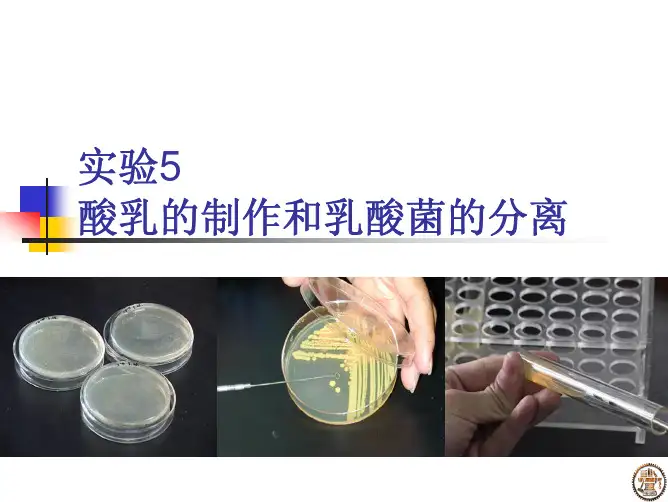

酸奶制作及乳酸菌的分离计数
- 格式:doc
- 大小:3.11 MB
- 文档页数:5

乳酸菌的分离及酸奶的制作一、乳酸细菌简介广义的乳酸菌是指一类能利用可发酵糖产生大量乳酸的细菌通称。
乳酸细菌不是一个分类学名称,在分类上乳酸细菌涉及的有关属在二十个属以上,常见的有:属于革兰氏阳性无芽孢杆菌的乳杆菌属(如德氏乳杆菌、保加利亚乳杆菌、干酪乳杆菌、植物乳杆菌);属于革兰氏阳性球菌的链球菌属(如嗜热链球菌)、乳球菌属(如乳酸乳球菌)、肠球菌属(如粪肠球菌【粪链球菌】)、明串珠菌属(如肠膜明串珠菌);属于不规则形的革兰氏阳性专性厌氧的双歧杆菌属(如两歧双歧杆菌);属于能形成内生孢子的芽孢杆菌属(如凝结芽孢杆菌、嗜热脂肪芽孢杆菌)等。
随着对细菌分类研究的不断深入,乳酸细菌的属种变动较大,而且新属、新种也不断涌现。
乳酸细菌分布广泛,在土壤、水体、植物(根际、果蔬表面等)、人和动物(肠道、口腔、呼吸道、生殖道等)、食品(乳品、发酵食品等)、动物饲料、粪便、污泥、临床样品中都有存在。
乳酸细菌与工业、农业、医药等领域关系密切,许多种类对人体和动物的健康有益,但也有相当一部分乳酸菌能使人畜致病。
二、制作酸奶中常用的乳酸菌及其生物学特性乳酸菌在食品工业中被广泛应用,使用的乳酸菌均对人体有益,常用于发酵乳制品、果蔬汁乳酸菌发酵饮料、泡菜和酸菜、微生态制剂(益生菌剂)等生产。
制作酸奶中常用的乳酸菌有保加利亚乳杆菌、嗜酸乳杆菌、嗜热链球菌、两歧双歧杆菌等。
多数为同型乳酸发酵,少数为异型乳酸发酵(如两歧双歧杆菌)。
1、双歧杆菌(Bifidobacterium)细胞呈Y字形、v字形、弯曲状、勺形等多样形态,典形形态为分叉杆菌,革兰氏染色阳性,亚甲基蓝染色菌体着色不规则,无芽孢和鞭毛,不运动。
化能异养型,对营养要求苛刻,生长繁殖需要多种双歧因子,能利用葡萄糖、果糖、乳糖和半乳糖,通过果糖-6-磷酸支路生成摩尔比2:3的乳酸和乙酸及少量的甲酸和琥珀酸,蛋白质分解力微弱,能利用铵盐作为氮源,不还原硝酸盐,不水解精氨酸,不液化明胶,不产生吲哚,联苯胺反应阴性。

酸奶的制作和品质检验**(海南大学**学院2011级,邮编:570228)指导老师:***(教授)摘要:以蒙牛鲜牛奶为原料,市售酸奶为接种剂自制酸奶并进行感官评价。
用稀释倒平皿法分离出蒙牛酸奶中的乳酸菌。
用改良MC培养基培养一段时间后观察菌落形态并进行菌落计数,算出所制作酸奶中乳酸菌的含量从而鉴定所制作酸奶的品质,一般来说,乳酸菌含量越高,酸奶品质越好。
关键词:酸奶制作;酸奶品质检验;乳酸菌菌落形态及计数酸奶是以新鲜的牛奶为原料,经过巴氏杀菌后再向牛奶中添加有益菌(发酵剂),经发酵后,再冷却灌装的一种牛奶制品。
酸奶酸奶营养丰富,其蛋白质和钙质较鲜乳更易消化吸收,抑制腐败细菌的繁殖,降低肠道内毒素浓度。
酸奶内含乳酸菌并在发酵过程中产生乳酸及族维生素等,能增强消化,促进肠道蠕动和机体物质的代谢,提高人的免疫力, 长期饮用即可保证钙质的需求, 又可健肠胃, 不但保留了牛奶的所有优点,而且某些方面经加工过程还扬长避短,是一种对人体肠胃非常有益的保健食品。
乳酸菌是一种存在于人类体内的益生菌。
乳酸菌能够将碳水化合物发酵成乳酸,因而得名。
益生菌能够帮助消化,有助人体肠脏的健康,因此常被视为健康食品,添加在酸奶之内。
代谢类型为异养厌氧型,是一种原核生物。
广泛存在于人、畜、禽肠道、许多食品、物料及少数临床样品中。
乳酸菌不仅可以提高食品的营养价值,改善食品风味,提高食品保藏性和附加值,而且,近年来乳酸菌的特殊生理活性和营养功能,正日益引起人们的重视。
大量研究表明,乳酸菌能够调节机体胃肠道正常菌群、保持微生态平衡,提高食物消化率和生物价,降低血清胆固醇,控制内毒素,抑制肠道内腐败菌生长繁殖和腐败产物的产生,制造营养物质,刺激组织发育,从而对机体的营养状态、生理功能、细胞感染、药物效应、毒性反应、免疫反应、肿瘤发生、衰老过程和突然的应急反应等产生作用。
由此可见,乳酸菌的生理功能与机体的生命活动息息相关。
可以说,如果乳酸菌停止生长,人和动物就很难健康生存。

酸奶制作及乳酸菌的分离计数1、实验目的1、学习自制酸奶的方法。
2、熟悉从酸奶中分离和纯化乳酸菌的一般方法。
3、掌握用浇注平板法分离微生物纯种。
4、了解简便、快速厌氧菌菌落计数法的基本原理。
5、学习用简便、快速厌氧菌菌落计数法对乳酸菌进行活菌计数。
二、实验原理酸奶又称酸乳,是以牛奶为主要原料,经乳酸菌发酵而制成的一种营养丰富、风味独特、国际流行的保健饮料。
酸奶发酵中的主要生物化学变化是:乳酸菌将牛奶中的乳糖发酵成乳酸使其pH降至酪蛋白等电点附件从而使牛奶形成凝固状;其次,乳酸菌还会触使部分酪蛋白降解、形成乳酸钙和产生一些脂肪、乙醛、双乙酰和定二酮等风味物质。
酸奶发酵过程通常是由双菌或多菌的混合培养实现的。
其中的杆菌先分解酪蛋白为氨基酸和小肽,由此促进球菌的生长,而球菌产生的甲酸又刺激了杆菌产生大量的乳酸和部分乙醛,由此链球菌还产生了双乙酰这类风味的物质,因此,达到了稳定状态的混合发酵。
根据高层半固体培养基具有良好厌氧性能的原理,我们设计了一种适用于乳酸菌等不产气的厌氧菌进行简便快速菌落计数的方法。
此法把稀释(在半固体培养基凝固前)和(在半固体培养基凝固后)集中在同一支试管中内,以不易透氧、装有高层半固体培养基的试管代替常规的培养皿平板进行菌落计数,从而使活菌计数操作简化成“试样分散----逐级稀释+常规培养---菌落计数”3步,而传统的方法则需“试样分散----逐级稀释---涂布或浇注平板---厌氧培养---菌落计数”5步。
因此,本法不仅有简化操作步骤的优点,还有省略专用厌氧培养装置、缩短培养时间以及节约试剂和材料等优点。
3、实验器材1、菌种:德氏乳杆菌保加利亚亚种、唾液链球菌嗜热亚菌(可从品牌酸奶商品中自行分离)2、培养基:(1)LAB半固体培养基100ml(2)MRS琼脂培养基200ml(3)MRS液体培养基10ml3、材料:优质全脂牛奶或奶粉(内含脂肪28%,蛋白石27%,乳糖37%,矿物质6%,水分2%),蔗糖:市售优质酸奶(1瓶)4、器皿:锥形瓶(3个)、空试管(14支)、无菌移液管(1ml*15根,10ml*2根)、培养皿(6套)、涂布棒、量筒、酒精灯、恒温水浴锅,恒温箱,冰箱4、实验步骤1、实验的准备(1)配制LAB半固体培养基100ml,MRS琼脂培养基200ml,MRS液体培养基10ml(2)用量筒各量取自来水225ml至2锥形瓶中,用移液管移取4.5ml至4支试管中(3)将培养基进行分装,用无菌移液管吸取9mlLAB半固体培养至6支试管中,用无菌移液管吸取5mlMRS液体培养基至2根试管中,用无菌移液管吸取10mlMRS琼脂培养基至2根试管中制作两个斜面(4)用报纸进行包扎试管,移液管,锥形瓶,培养皿,然后放入灭菌锅进行灭菌2、酸奶的制作(1)配奶:在牛奶中添加6%~10%蔗糖后搅匀。

发酵工程学实验报告实验三、乳酸菌的分离和酸奶的制作学院生命科学学院专业应用生物教育班级12应生A班姓名李顺昌学号124120218实验课程乳酸菌的分离和酸奶的制作指导教师许波开课学期2014—2015学年下学期实验三、乳酸菌的分离和酸奶的制作小组合作:是小组成员:李顺昌、李媛媛、方淑萍、周玉坤一、实验目的1.掌握分离纯化微生物的基本方法2.掌握酸奶制作的基本原理3.学会酸奶的制作方法二、实验设备与材料1、仪器设备:三角瓶、平皿、试管、移液管、玻璃涂布棒、灭菌锅、超净工作台、培养箱、恒温摇床、冰箱等。
2、材料:市售酸奶、奶粉、白糖、棉花、酸奶瓶(自备,1个/人)等。
3、培养基:乳酸菌分离用乳酸菌分离用培养基:牛肉膏:0.5%;酵母膏:0.5%;蛋白胨:1%;葡萄糖:1%;乳糖:0.5%;NaCl:0.5%;琼脂:2.5%;pH6.8。
配制250mL/组,装于2个三角瓶三、实验原理1、酸奶制作的基本原理(1)酸奶:以牛奶为主要原料,接入一定量乳酸菌,经发酵后制成的一种乳制品饮料。
(2)生理生化原理牛奶(乳糖)→接种乳酸菌→β-D-半乳糖苷酶→乳糖(半乳糖和葡萄糖)→乳酸发酵(葡萄糖)→乳酸→破坏钙-酪蛋白-磷酸复合物的稳定性→蛋白质凝结→酸奶2、提供适宜的生长条件、采用一定的微生物分离纯化方法,就能够从酸奶中分离出乳酸菌。
3、酸奶中含有乳酸菌的菌体及代谢产物,因而对人体的肠胃消化道疾病有良好的治疗效果。
四、实验方法步骤(一)乳酸菌的分离纯化——稀释涂布平板法1、倒平板(约6块/100ml)2、制备酸奶稀释液(1)将0.5mL酸奶吸入4.5mL无菌水(自备)中,摇动5min;(2)用无菌吸管吸出0.5mL酸奶悬液,加入盛有4.5mL无菌水的试管中,充分混匀,制备得到10-2稀释液;(3)再从中吸出0.5mL加入盛有4.5mL无菌水的大试管中,混匀后得到10-3稀释液;(4)以此类推,分别制备得到10-4、10-5、10-6酸奶稀释液。

实验乳及乳制品中乳酸菌的测定一、目的1、解酸乳中乳酸菌分离原理2、学习并掌握酸乳中乳酸菌菌数的检测方法。
二、原理活性酸奶需要控制各种乳酸菌的比例,有些国家将乳酸菌的活菌数含量作为区分产品品种和质量的依据。
由于乳酸菌对营养有复杂的要求,生长需要碳水化合物、氨基酸、肽类、脂肪酸、酯类、核酸衍生物、维生素和矿物质等,一般的肉汤培养基难以满足其要求。
测定乳酸菌时必须尽量将试样中所有活的乳酸菌检测出来。
要提高检出率,关键是选用特定良好的培养基。
采用稀释平板菌落计数法,检测酸奶中的各种乳酸菌可获得满意的结果。
三、材料1、培养基改良MC培养基(MRS培养基,改良CHALMERS培养基,M17培养基)。
2、仪器和器具无菌移液管(25ml,1ml),无菌水(225ml带玻璃珠三角瓶,9ml试管),无菌培养皿,旋涡均匀器,恒温培养箱。
四、流程酸奶→稀释→制平板→培养→检查计数五、方法1、样品稀释先将酸奶样品搅拌均匀,用无菌移液管吸取样品25ml加入盛有225ml无菌水的三角瓶中,在旋涡均匀器上充分振摇,务必使样品均匀分散,即为10-1的样品稀释液,然后根据对样品含菌量的估计,将样品稀释至适当的稀释度。
2、制平板选用2~3个适合的稀释度,培养皿贴上相应的标签,分别吸取不同稀释度的稀释液1ml 置于平皿内,每个稀释度作2个重复。
然后用溶化冷却至45℃左右的MC培养基倒平皿,迅速转动平皿使之混合均匀,冷却成平板。
3、培养和计数将平皿倒置于37℃恒温箱内培养72h,观察长出的细小菌落,计菌落数目,按常规方法选择30~300个菌落平皿进行计算。
六、结果1、指示剂显色反应乳酸菌的菌落很小,1~3mm,圆形隆起,表面光滑或稍粗糙,呈乳白色、灰白色或暗黄色。
由于产酸菌落周围能使CaCO3产生溶解圈,酸碱指示剂呈酸性显色反应。
2、镜检形态必要时,可挑取不同形态菌落制片镜检确定是乳杆菌或乳链球菌。
保加利亚乳杆菌呈杆状,成单杆、或双杆菌或长丝状。

酸奶中乳酸菌的检测与酸奶的制作综合性实验报告组员:摘要:以奶粉为原料,蒙牛酸奶为接种剂自制酸奶并进行感官评价。
用稀释倒平皿法和划线分离法分离出蒙牛酸奶中的乳酸菌。
分别用改良MC培养基和改良TJA培养基培养一段时间后观察菌落形态并进行菌落计数。
再挑取少许不同培养基上的菌落用革兰氏染色法染色,观察乳酸菌的个体形态。
关键词:酸奶制作、乳酸菌菌落形态及总数、MC培养基、TJA培养基、革兰氏染色、乳酸菌个体形态1 前言酸奶是以新鲜的牛奶为原料经过巴氏杀菌后再向牛奶中添加有益菌(发酵剂),经发醇后,再冷却灌装的一种牛奶制品。
按是否加糖,酸奶可分为淡酸奶和加糖酸奶两种,我国常见的酸奶制品是加糖酸奶,即在制作酸奶的原料乳中加入一定量的白糖进行发酵得到的酸奶产品。
酸奶营养丰富,其蛋白质和钙质较鲜乳更易消化吸收,抑制腐败细菌的繁殖,降低肠道内毒素浓度。
酸奶内含乳酸菌并在发酵过程中产生乳酸及族维生素等,能增强消化,促进肠道蠕动和机体物质的代谢,提高人的免疫力, 长期饮用即可保证钙质的需求, 又可健肠胃, 是一种对人体肠胃非常有益的保健食品。
2 材料与方法2.1 仪器与器材温箱:47℃、冰箱: 4℃、电磁炉、锅吸管:容量为1,10和25mL、广口瓶或三角瓶:容量为500mL、平皿:直径为9cm、试管(带试管塞):18×180mm、显微镜、带玻璃珠的三角瓶、移液枪、移液管、恒温箱、电磁炉、平底锅、2个奶瓶、保鲜膜、接种环、酒精灯。
2.2 培养基和试剂培养基:改良MC 培养基,改良TJA培养基。
材料:番茄汁、革兰氏染色液、蒙牛酸奶、脱脂奶粉、白砂糖。
2.3 方法2.3.1 无菌水和培养基的制备(1)无菌水:将20支试管分别用移液枪注入9ml的自来水,塞上试管塞,分10支捆成一扎并用牛皮纸包好。
将2个三角瓶分别注入150ml的自来水,塞上瓶塞,分别用牛皮纸封好。
将上述的试管以及三角瓶一起高压蒸汽灭菌。
(2)培养基:MC培养基:称取16g改良MC培养基粉末加200mL水置于电炉上小火加热溶解;TJA培养基:称取12g改良TJA培养基粉末加10mL茄汁和200mL水置于电炉上小火加热溶解,分别制得。

乳酸菌的分离及乳酸菌发酵的实验方案一.实验材料:新鲜乳酸饮料(20ml)、脱脂奶粉(140g)(345g)、蔗糖(20g)、1.6%溴甲酚绿乙醇溶液(溴甲酚绿、无水乙醇、1ml)、酵母膏(10g)、琼脂(20g)、革兰氏染液(结晶紫染液、卢戈氏碘液、95%乙醇、沙黄)、75%乙醇、香柏油、1mol/L NaOH、1mol/L HCl、碳酸钙等二.实验仪器与设备高压蒸汽灭菌锅、恒压干热灭菌箱、超净工作台、光学显微镜、培养箱、pH试纸、酸乳瓶(9~15)、培养皿(φ90或φ120mm)(4)、试管、300ml三角瓶(带玻珠)、移液管、天平、牛角匙、电炉、量筒、漏斗、漏斗架、玻璃棒、棉塞、吸管、线绳、标签、500ml锥形瓶、250ml锥形瓶、250ml烧杯、酒精灯、石棉网、接种针(环)、擦镜纸三.实验步骤步骤总思路:菌种的分离、纯化(五天半)↓菌种的鉴别(半天)↓饮料培养基质的制作(一天)↓接种、乳酸发酵(一天半)Ⅰ、菌种分离培养BCG牛乳培养基的配制:(A)溶液—脱脂乳粉100g,水500ml,加入1.6%溴甲酚绿(BCG)乙醇溶液1ml,80℃灭菌20min;(B)溶液—酵母膏10g,水500ml,琼脂20g,PH6.8,121℃湿热灭菌20min,以无菌操作趁热将A﹑B溶液混合后倒平板。
样品的处理:按照无菌操作要求,从市售新鲜酸乳中吸取10ml检样,放入装有90ml 无菌水的三角瓶内,振摇混匀;用十倍稀释法稀释成10-1、10-2、10-3、10-4、10-5各种稀释度的样品液。
平板划线分离:直接用接种环蘸取10-4、10-5 两个稀释度的试管中原液,在BCG牛乳培养基琼脂平板上划线分离,每稀释度做两个平皿。
置40℃培养箱中培养48h。
如出现圆形稍扁平的黄色菌落及周围培养基变为黄色者初步定为乳酸菌。
Ⅱ、菌种纯化配制脱脂乳试管培养基、分装、包扎,灭菌备用脱脂乳试管培养基成分:20g脱脂奶粉,200ml灭菌水、10g蔗糖把配置好的脱脂乳培养基分装到15支试管中选取经初步鉴定的乳酸菌典型菌落,用接种环挑取转至脱脂乳试管中,40℃培养箱中培养8~24h。

酸奶中乳酸菌的分离与纯化一、实验目的1.掌握分离乳酸菌的基本原理和操作技术;2.学习并掌握稀释法和微生物纯培养操作。
二、实验设备及材料培养基材料:牛肉膏、蛋白胨、酵母膏、番茄汁、葡萄糖、吐温、溴甲酚绿、琼脂。
实验材料:无菌水、培养皿、电热套、高压蒸汽灭菌锅、电子分析天平、涂布棒、酒精灯、无菌试管、移液枪、无菌吸管。
三、实验原理乳酸菌指发酵糖类主要产物为乳酸的一类无芽孢、革兰氏染色阳性细菌的总称。
大多数不运动,少数以周毛运动。
菌体常排列成链。
根据细胞形态分为球状或杆状,可分为两大类,即乳酸链球菌和乳酸杆菌。
在乳酸菌培养基平板上,乳酸菌菌落大约1~3mm,圆形隆起,表面光滑,呈乳白色、灰白色或暗黄色;在产酸周围还能产生CaCO3溶解圈。
乳酸菌革兰氏染色后呈蓝色,为革兰氏阳性菌。
四、实验步骤1.乳酸菌培养基的制作配方蛋白胨 2.0g酵母膏 2.0g番茄汁40g葡萄糖 2.0g吐温0.10mL碳酸钙 3.4g溴甲酚绿0.02g琼脂2~4g水200mL①称量:按照培养基配方依次称取药品放入烧杯中。
②熔化:在烧杯中加入略少于200mL水,加热至沸腾。
依次加入药品,用玻璃棒不断搅拌,待其完全溶解后,加入琼脂,搅拌至完全熔化,最后补足所损失的水分。
③分装:将配置的乳酸菌培养基装入三角瓶中。
④加棉塞、包扎⑤灭菌:将乳酸菌培养基在压力0.11MPa,温度121℃条件下灭菌20min。
⑥无菌检查2.倒平板将乳酸菌培养基熔化,待冷却至55~60℃时,倒平板,倒好后,在室温下培养2~3d,或37℃培养24h,检查无菌落及皿盖无冷凝水后再使用。
3.制备稀释液量取酸奶10mL,放入盛有90 mL无菌水并带有玻璃珠的三角烧瓶中,震摇约20min,使酸奶与无菌水充分混合,将酸奶分散。
用一只1 mL无菌吸管从中吸取1 mL酸奶悬浊液注入盛有9 mL无菌水的试管中,吹吸三次,使充分混匀。
然后再用一支1 mL无菌吸管从此试管中吸取1 mL注入另一盛有9 mL无菌水的试管中,以此类推,制成10−3、10−4、10−5各种稀释度的酸奶稀释液。

乳酸菌的分离及酸奶的制作乳酸菌是一类广泛存在于自然界中的微生物,常见于发酵食品中,特别是酸奶中。
乳酸菌通过产酸作用,可以改变食品的酸碱度,增强味道和保存食品的能力。
因此乳酸菌的分离和酸奶的制作具有重要的实际意义。
1.选择合适的发酵食品作为样品,如酸奶或发酵乳。
2.将样品进行稀释,然后分别接种在适宜的培养基上,如牛乳琼脂培养基或MRS培养基。
3.培养基应保持在适宜的温度,通常是37°C,促使细菌的生长。
4.观察培养基上的菌落形态,标记明显异于其他菌落的菌落。
5.使用无菌技术,将单独的菌落分离到新的培养基上。
6.对新培养的乳酸菌菌株进行纯化和鉴定,如形态学观察、生理生化特性检测等。
酸奶的制作主要是通过乳酸菌进行发酵来实现的,以下是一种常见的酸奶制作方法:1.选择新鲜的牛乳作为原料,最好使用全脂牛乳,因为全脂牛乳中的脂肪能够提供乳酸菌生长所需的营养。
2.将牛乳煮沸并冷却至40-45°C,这是乳酸菌生长的最适温度。
3.加入适量的酸奶发酵剂,这可以是商业化的酸奶菌干粉或者是之前分离得到的纯化乳酸菌菌株。
4.用搅拌器均匀地搅拌牛乳,以确保发酵剂充分混合。
5.将搅拌均匀的牛乳倒入适宜的容器中,并加盖保温。
可以使用保温箱或温暖的地方来保持发酵温度。
6.将容器放置在温暖的地方,保持温度在37-43°C之间,使乳酸菌进行发酵。
发酵时间通常为6-8小时,但可以根据个人口味和偏好进行调整。
7.发酵完成后,将酸奶放入冰箱冷藏,以停止乳酸菌的发酵过程。
8.酸奶制作完成后,可以根据个人口味添加适量的糖、水果、坚果等作为调味品。
通过乳酸菌的分离和酸奶的制作,我们可以获得高质量的酸奶产品,并且能够自己调整酸奶口味和营养成分。
此外,乳酸菌的分离和酸奶制作对于学术研究和食品工业也具有重要意义,可以深入了解乳酸菌的功能和应用,以及改善食品的质量和口感。

一、实验目的1. 了解酸奶制作过程中微生物的变化规律。
2. 掌握酸奶中主要微生物的种类和数量。
3. 分析酸奶制作过程中微生物的发酵作用。
二、实验原理酸奶是以鲜奶为原料,通过乳酸菌的发酵作用,使乳糖转化为乳酸,从而使牛奶变为具有酸味、凝乳状态的乳制品。
本实验主要检测酸奶中的乳酸菌数量,以了解酸奶制作过程中微生物的变化规律。
三、实验材料1. 实验仪器:恒温培养箱、无菌操作台、显微镜、无菌培养皿、移液器、酒精灯等。
2. 实验试剂:MRS培养基、生理盐水、无菌水等。
3. 实验样品:自制酸奶、市售酸奶。
四、实验方法1. 样品制备:将自制酸奶和市售酸奶分别进行10倍梯度稀释。
2. 培养基制备:将MRS培养基在121℃高压灭菌15分钟,冷却至50℃左右加入适量的生理盐水,混匀后倒入无菌培养皿中,待凝固后备用。
3. 涂布接种:将稀释后的酸奶样品用无菌移液器吸取一定量,涂布在MRS培养基上,重复3次。
4. 培养:将涂布好的培养皿置于37℃恒温培养箱中培养24小时。
5. 计数:观察培养基上的菌落生长情况,统计菌落数量。
五、实验结果与分析1. 自制酸奶中乳酸菌数量为10^7 CFU/g,市售酸奶中乳酸菌数量为10^8 CFU/g。
2. 自制酸奶中其他微生物数量较少,市售酸奶中其他微生物数量较多。
六、实验结论1. 自制酸奶和市售酸奶中均含有大量的乳酸菌,符合酸奶的制作要求。
2. 自制酸奶中其他微生物数量较少,说明自制酸奶的卫生条件较好。
3. 酸奶制作过程中,乳酸菌的发酵作用对酸奶的品质具有重要影响。
七、实验讨论1. 本实验结果表明,自制酸奶和市售酸奶中均含有大量的乳酸菌,符合酸奶的制作要求。
2. 在酸奶制作过程中,要严格控制卫生条件,避免其他微生物的污染。
3. 酸奶的品质与乳酸菌的种类和数量密切相关,可以通过调整发酵条件来提高酸奶的品质。
八、实验建议1. 在酸奶制作过程中,要注重原料的选择和卫生条件的控制,以保证酸奶的品质。
实验室发酵步骤流程实验一酸奶的制作与乳酸菌的活菌计数(5学时)实验目的:1.学习并掌握酸奶制作的基本原理与方法。
2.了解市售酸奶的生产工艺。
3.掌握乳酸菌活菌计数方法与操作。
实验原理: 乳酸菌在乳中生长繁殖,发酵分解乳糖产生乳酸等有机酸,导致乳的pH值下降,使乳酪蛋白在其等电点附近发生凝集。
乳酸菌属于兼性厌氧微生物,在无氧条件下生长繁殖较好,实验室条件下利用混菌培养的方法,尽可能让乳酸菌在无氧条件下生长,每个单菌落代表一个微生物细胞。
实验内容:(一)酸奶制作1、10%脱脂奶粉溶解于热水(80℃左右)中,充分搅拌均匀,配成调制乳;2、添加蔗糖:为了缓和酸奶的酸味,改善酸奶口味,在调制乳中加人4-8%的蔗糖。
3、灭菌:方法有两种:将乳加热至90℃,保温5min;4、接种:往冷却到43-45℃灭过菌的乳中加入乳酸菌,接种量为2%-5%。
5、分装:酸奶受到振动,乳凝状态易被破坏,因此,不能在发酵罐容器中先发酵然后再进行分装,须是将含有乳酸菌的牛乳培养基先分装到小容器中,加盖后送入恒温室培养,在小容器中发酵制成酸奶。
6、发酵:发酵的温度保持在40-43 ℃,一般发酵时间为3-6h。
发酵终点的确定有两种方法: 1)检测发酵奶的酸度,达到65-70 T°。
2)倾斜观察,瓶内酸奶流动性差,而且瓶中部有细微颗粒出现。
7、冷却:发酵结束,将酸奶从发酵室取出,用冷风迅速将其冷印到10℃以下,一般2 h,使酸奶中的乳酸菌停止生长,防止酸奶酸度过高而影响口感。
8、冷藏和后熟:经冷却处理的酸奶,贮藏在2-5℃的冷藏室中保存。
9、感官指标: 1)色泽:色泽均匀一致,呈乳白色,或稍带微黄色。
2)组织状态:凝块稠密结实均匀细腻,无气泡,允许少量乳清析出。
3)气味:具有清香纯净的乳酸味,无酒精发酵味,无霉味和其他外来不良气味。
(二)乳酸菌活菌检测1.检测培养基:蛋白胨15g,牛肉膏5g,葡萄糖20g,氯化钠5g,碳酸钙10g, 琼脂粉20g,水1000ml,115~121℃灭菌20min,灭菌后放置水浴52℃保温备用。
实验四鲜奶的乳酸发酵及乳酸杆菌的分离纯化一、实验目的1.掌握酸奶的制作工艺;2.掌握乳酸杆菌发酵鲜奶的原理;3.掌握分离纯化乳酸杆菌的方法.二、实验原理无氧,菌乳酸菌糖乳酸酸奶酸奶发酵过程是双菌或多菌的混合培养实现的。
酪蛋白小肽或氨基酸促进球菌生长、甲酸促进杆菌产生中间有大量的乳酸、乙醛、双乙酰产生乳酸菌发酵过程是双菌或多菌的混合培养实现的,酪蛋白分离成小肽或氨基酸,促进球菌的生长,产生大量的乳酸、乙醛、双乙酰。
乳酸菌利用牛奶为底物进行厌氧发酵,得到主要发酵产物乳酸。
三、实验材料与仪器材料:纯牛奶,乳酸菌(益力多),白砂糖;仪器:高压灭菌锅、恒温培养箱。
四、实验步骤(一)酸奶的制作1、配奶:150mL的纯牛奶加15~20g白砂糖,搅拌好,砂糖需完全溶解;2、接种:按总体150mL鲜奶加15mL益力多,桌面上水平摇匀10min;3、装瓶4、保温:40~42度,3~4h,常观察,整瓶上下层均出现凝乳时停止培养,转至4~5度低温下冷藏1~2h。
5、加热:低温后加热6、品尝:口感与风味接种剂品牌PH 凝结程度口感香味异味品评益力多 6.0 无凝结甜,无酸味奶香无太甜(二)乳酸杆菌的分离纯化益力多中乳酸菌的分离,按10倍稀释法,原液大约为109/mL编号 1 2 3 4 5 6 7 810倍108/mL 107/mL 106/mL 105/mL 104/mL 103/mL 102/mL 10/mL 划线法每组做四种浓度,每种浓度2个平行,划八个皿,37度倒置培养。
纯化:划线,染色(划一个单菌落在载玻片,用10uL的水涂匀,烤干,加一滴美篮染色,烤干,加香柏油,在油镜下观察)分离:取以上培养的两个浓度,分别取一个单菌落接到一个新的培养皿上,同样条件继续培养。
五、结果与讨论1、鲜奶的乳酸发酵图一图二图一图二便是我做的乳酸发酵结果,从图中可以明显的看到奶瓶中并未出现凝结情况,牛奶还是呈现液状,开启品尝后发现口味很甜,似乎乳酸菌并未利用糖进行发酵或者是因为我们使用的从超市买回来的罐装鲜奶中含有较高浓度的防腐剂,从而抑制乳酸菌的生长,导致乳酸菌的发酵能力大打折扣,因此鲜奶并未如预期那样成功发酵成酸奶。
乳酸菌的分离鉴定与酸奶的发酵及检测陈园园(中北生物技术1803108)摘要:乳酸菌:一群或几种能分解葡萄糖或乳糖产生乳酸,需氧和兼性厌氧,多数无动力,过氧化氢酶阴性,革兰氏阳性的无芽胞杆菌和球菌。
如保加利亚乳杆菌、嗜热乳链球菌、嗜酸乳杆菌。
酸奶发酵基本原理是通过乳酸菌发酵牛奶中的乳糖产生乳酸。
乳酸使牛奶中酪蛋白(约占全乳的2.9%,占乳蛋白的85%)变性凝固而是整个奶液呈凝乳状态。
同时,通过发酵还可形成酸奶特有的香味和风味。
按凝固状态可将酸奶分为凝固型酸奶和搅拌型酸奶,二者基本工艺过程相似。
发酵剂的制备分三个阶段,即乳酸菌纯培养物、母发酵剂和生产发酵剂。
实验分离得到的嗜热乳酸链球菌(Streptococcus thermophilus),培养基使用脱脂乳粉或全脂乳粉、鲜牛奶、蔗糖。
关键词:乳酸菌、酪蛋白前言:乳酸菌是指一群通过发酵糖类,产生大量乳酸的细菌总称。
乳酸从形态上可分为球菌和杆菌,并且均为革兰氏染色阳性、在缺少氧气的环境中生长良好的兼性厌氧性或厌氧性细菌。
目前,对乳酸菌的应用研究,着重于食品(如发酵乳制品、发酵肉制品和泡菜)和医药工业等人类生活密切相关的领域。
近几年由于广谱和强力的抗菌素的广泛应用,使人体肠道内以乳酸菌为主的益生菌遭受到严重破坏,抵抗力逐步下降,导致疾病越治越多,健康受到极大的威胁。
所以,有意增加人体肠道内乳酸菌的数量就显得非常重要。
随着人们生活水平的提高和消费观念的转变,在我国生产销售的酸乳及酸乳饮品数量直线上升, 品种花样繁多, 很受消费者的青睐。
酸奶是以新鲜牛乳经有效杀菌, 用不同乳酸菌发酵剂制成的乳制品, 味酸甜细腻, 营养丰富, 深受人们喜爱, 专家称它是“21 世纪的绿色食品”, 是一种“功能独特的营养品”。
它对人体有较多的好处, 可以维持肠道正常菌群平衡, 调节肠道有益菌群到正常水平等。
因此,从发酵乳制品中分离性能优良的乳酸菌,制作真正的健康、绿色的食品,对促进我国发酵乳制品工业的发展具有重要的意义。
乳酸菌饮料中乳酸菌的微生物学检验与酸奶的制作摘要本实验选用达能酸奶作为材料,通过制作改良MC和改良TJA两种培养基,观察分析比较达能酸奶在两种培养基中生成菌落的异同,并以达能酸奶作为菌源接种到奶粉液中制作酸奶,对所得酸奶进行感官评定,讨论影响菌落生成及酸奶感官的因素。
关键词:酸奶乳酸菌菌落形态菌落总数感官评价前言酸奶为纯绿色食品, 它是由牛奶经乳酸菌发酵制成的, 除具有鲜牛奶的营养价值外, 因内含乳酸菌并在发酵过程中产生乳酸及B族维生素(B2、B6、B12)等,可促进人体消化呼吸, 提高人的免疫力, 长期饮用既可保证钙质的需求, 又可健肠胃, 调节人体代谢,提高人的抗病能力, 使人健康长寿[1]。
酸奶中的乳酸菌主要有乳杆菌、双歧杆菌和片球菌三个属,它们能够定植在人体内,起到改善营养健康状况、改善胃肠道功能、改善免疫能力、抗有害菌和抗衰老的作用[2]。
对酸奶中的这些益生菌进行研究,有助于了解酸奶的保健原理,对制作更加营养、更优质的酸奶具有指导意义。
1 材料与方法1. 1 仪器与材料1. 1. 1 仪器玻璃瓶(无盖,2个),电磁炉(带不锈钢锅),不锈钢杯,移液管及移液管筒,电子天平,量筒,具塞锥形瓶(带玻珠,3个),具塞试管(7支),培养皿(16个),接种环,酒精灯,载玻片(4片),光学显微镜。
1. 1. 2 材料达能酸奶,脱脂奶粉,白砂糖,MC培养基粉末,TJA培养基粉末,擦镜纸,吸水纸,牛皮纸,保鲜膜,橡皮筋。
1. 2 培养基和试剂1. 2. 1 改良MC培养基(每升)大豆蛋白胨5g,牛肉膏粉5g,酵母膏粉5g,葡萄糖20g,乳糖20g,碳酸钙10g,琼脂15g,中性红0.05g,最终pH6.0±0.2。
1. 2. 2 改良TJA培养基(每升)[3]番茄汁50mL,酵母抽提液5g,肉膏10g,乳糖20g,葡萄糖2g,K2HPO42g,吐温-80 1g,乙酸钠5g,琼脂15g,最终pH6.8±0.2。
酸奶中优势微生物的分离及乳酸菌饮料的制作滕小艳生命科学学院生物科学专业2006级1班指导老师:宋波摘要:为了解我们日常饮用的酸奶中益生菌的基本情况,本次实验通过酸奶的制作,菌种的活化,传代,分离鉴定和平板划线等方法,对其中的2种菌进行镜检和革兰氏染色以确定其类型,;然后用1种或2种等量混合的方法,发酵制成的产品,比较其发酵性能。
结论:在琼脂培养基上,圆形稍扁平的黄色菌落,及其周围培养基变为黄色者,即为乳酸菌。
乳酸菌根据细胞为球状或杆状,可分为两大类,即为乳酸链球菌和乳酸杆菌族。
嗜酸乳杆菌和嗜热链球菌混合发酵的酸奶风味明显优于嗜酸乳杆菌单独发酵。
凝乳时间也大为缩短。
关键字:保加利亚乳杆菌嗜酸乳杆菌嗜热链球菌革兰氏染色混合发酵Yogurt microorganisms and lactobacillus drink productionTengXiaoYanLife science college of biological science class 1 grade 2006 ,instructor: song boAbstract: in order to understand our everyday drinkable probiotic yogurt, the basic condition of this experiment through, yogurt, strains of activation, separation and identification of flat nestin crossed, the method of the two kinds of bacteria for gram's staining and to determine the types. Then use one or two equal mixing method, fermented product, compares the performance of fermentation.Conclusion: in AGAR medium, circular slightly flat yellow, and its surrounding medium colony, to become yellow lactobacillus. According to the cells to aspen, globular or can be divided into two categories, namely, streptococcus and lactobacillus to lactic acid. Acidophilus andKey words:Bulgaria lactobacillus acidophilus streptococcus thermophilus cultured mixed fermentation gram's staining.嗜酸乳杆菌存在于人类和一些动物的小肠内,它在代谢过程中产生能产生乳酸﹑过氧化氢﹑乳酸杀菌素和类细菌素,从而抑制肠道内有害菌的生长,调整胃肠环境,同时嗜酸乳杆菌还有防治结肠癌和降低体内胆固醇的作用。
乳酸菌分离制作酸奶的实验报告实验报告:乳酸菌分离制作酸奶摘要:本实验旨在通过分离乳酸菌并制作酸奶的方法,检验其对牛奶的发酵作用及产酸能力。
首先,使用MRS琼脂培养基筛选出乳酸菌,然后将筛选得到的乳酸菌培养至稳定并筛选出最优菌株。
在石蜡油浴中控制发酵温度,制作乳酸酸奶。
结果显示,乳酸菌具有发酵能力,并能将牛奶转化为酸奶。
本实验结果可为酸奶生产工艺提供一定的理论依据。
关键词:乳酸菌、酸奶、分离、发酵、牛奶引言:酸奶是一种由牛奶经乳酸菌发酵制成的乳制品。
它具有很高的营养价值和保健功效,对人体健康有益。
酸奶的制作过程主要依赖于乳酸菌的发酵作用将牛奶中的乳糖转化为乳酸。
因此,充分了解乳酸菌的发酵特性对于酸奶的生产具有重要意义。
实验目的:1.分离筛选具有较高产酸能力的乳酸菌。
2.探索乳酸菌对牛奶的发酵作用。
3.制作乳酸酸奶并评估其质量。
材料与方法:1.材料:酸奶、牛奶、MRS琼脂培养基、蒸馏水。
2.仪器:培养皿、试管、恒温培养箱、石蜡油浴。
3.方法:a.分离乳酸菌:取适量酸奶和牛奶混合,均匀地涂抹在MRS琼脂培养基上,培养于恒温培养箱中37℃下48小时。
b.从培养基上选择纯培养基成独立菌落的乳酸菌,接种于MRS培养基中,再次传代定植。
c.选择最优菌株:通过观察不同菌落的形态和产酸量,在接种过程中筛选出最优菌株。
d.制作酸奶:取适量最优菌株培养物,加入5%的牛奶中,加入酸奶中的菌株用于酸奶制作。
将牛奶菌株混合物放入石蜡油浴中,保持恒温(42℃)发酵约12小时。
e.评估酸奶质量:检测酸奶的质地、味道和酸度。
结果与讨论:通过上述实验步骤,我们成功地分离出多株产酸能力较高的乳酸菌,并筛选出最优菌株。
经过发酵,最优菌株能够将牛奶发酵为酸奶,酸奶的质地、味道和酸度也得到了良好的保持。
这说明最优菌株的发酵作用有效,并能将牛奶中的乳糖转化为乳酸。
酸奶的产酸性能使其具有更好的口感和营养特性。
结论:本实验成功地分离出产酸能力较高的乳酸菌,并以之制作了酸奶。
酸奶制作及乳酸菌的分离计数
一、实验目的
1、学习自制酸奶的方法。
2、熟悉从酸奶中分离和纯化乳酸菌的一般方法。
3、掌握用浇注平板法分离微生物纯种。
4、了解简便、快速厌氧菌菌落计数法的基本原理。
5、学习用简便、快速厌氧菌菌落计数法对乳酸菌进行活菌计数。
二、实验原理
酸奶又称酸乳,是以牛奶为主要原料,经乳酸菌发酵而制成的一种营养丰富、风味独特、国际流行的保健饮料。
酸奶发酵中的主要生物化学变化是:乳酸菌将牛奶中的乳糖发酵成乳酸使其pH降至酪蛋白等电点附件从而使牛奶形成凝固状;其次,乳酸菌还会触使部分酪蛋白降解、形成乳酸钙和产生一些脂肪、乙醛、双乙酰和定二酮等风味物质。
酸奶发酵过程通常是由双菌或多菌的混合培养实现的。
其中的杆菌先分解酪蛋白为氨基酸和小肽,由此促进球菌的生长,而球菌产生的甲酸又刺激了杆菌产生大量的乳酸和部分乙醛,由此链球菌还产生了双乙酰这类风味的物质,因此,达到了稳定状态的混合发酵。
根据高层半固体培养基具有良好厌氧性能的原理,我们设计了一种适用于乳酸菌等不产气的厌氧菌进行简便快速菌落计数的方法。
此法把稀释(在半固体培养基凝固前)和(在半固体培养基凝固后)集中在同一支试管中内,以不易透氧、装有高层半固体培养基的试管代替常规的培养皿平板进行菌落计数,从而使活菌计数操作简化成“试样分散----逐级稀释+常规培养---菌落计数”3步,而传统的方法则需“试样分散----逐级稀释---涂布或浇注平板---厌氧培养---菌落计数”5步。
因此,本法不仅有简化操作步骤的优点,还有省略专用厌氧培养装置、缩短培养时间以及节约试剂和材料等优点。
三、实验器材
1、菌种:德氏乳杆菌保加利亚亚种、唾液链球菌嗜热亚菌(可从品牌酸奶商品中自行
分离)
2、培养基:(1)LAB半固体培养基100ml
(2)MRS琼脂培养基200ml
(3)MRS液体培养基10ml
3、材料:优质全脂牛奶或奶粉(内含脂肪28%,蛋白石27%,乳糖37%,矿物质6%,水分2%),蔗糖:市售优质酸奶(1瓶)
4、器皿:锥形瓶(3个)、空试管(14支)、无菌移液管(1ml*15根,10ml*2根)、培养皿(6套)、涂布棒、量筒、酒精灯、恒温水浴锅,恒温箱,冰箱
四、实验步骤
1、实验的准备
(1)配制LAB半固体培养基100ml,MRS琼脂培养基200ml,MRS液体培养基10ml
(2)用量筒各量取自来水225ml至2锥形瓶中,用移液管移取4.5ml至4支试管中
(3)将培养基进行分装,用无菌移液管吸取9mlLAB半固体培养至6支试管中,用无菌移液管吸取5mlMRS 液体培养基至2根试管中,用无菌移液管吸取10mlMRS琼脂培养基至2根试管中制作两个斜面
(4)用报纸进行包扎试管,移液管,锥形瓶,培养皿,然后放入灭菌锅进行灭菌
2、酸奶的制作
(1)配奶:在牛奶中添加6%~10%蔗糖后搅匀。
(2)消毒:将酸奶原料置于85~90℃下消毒15min
(3)冷却:将消毒后的牛奶冷却至45℃左右
(4)接种:按5%~10%(V/V)比例将市售优质酸奶作菌种接入冷却牛奶中,充分搅匀
(5)装瓶:将上述牛奶按无菌操作灌入无菌三角瓶中,每瓶灌装量约为250g(使液面距瓶口1.5cm)(6)保温:将接种后的牛奶置于40~42℃的恒温箱中保温3~4h(具体时间视凝乳速度而定)
(7)后熟:已形成凝胶状态的酸奶在4℃左右的低温下保持12~24h,以使其后熟(后发酵)
(8)品味:评定酸乳质量有理化指标和微生物学指标两类。
品尝时有良好口感和风味,同时观察产品的外观,包括凝块状态、色泽洁白度、表层光洁度、无气泡和具有悦人香味等。
相反,若品尝时发现有异味时则说明发酵中污染了杂菌
3、乳酸菌的分离
(1)培养皿编号:取6只培养皿,分别编上10-4、10-5和10-63种稀释度(各两皿)
(2)稀释菌样:吸取25ml酸奶至一锥形瓶中,摇匀,再吸取25ml至另一锥形瓶中,取4支试管,依次编号10-3-10-6,在各管中分别加入无菌水4.5ml,然后逐级稀释
(3)吸取菌液:从10-4、10-5和10-6各管中,分别吸出0.2ml菌液加至相应编号的无菌培养皿中
(4)浇培养基:向各培养皿中分别倒入充分融化并冷却至45℃左右的LAB半固体培养基,并立即将菌液和培养基充分均匀,并立即放平,待凝
(5)恒温培养:将含菌平板倒置,在37℃恒温培养箱中培养24h左右
(6)挑单菌落:用灭菌后的接种环挑取单菌落至试管斜面,恒温培养
4、乳酸菌的计数
(1)准备试样:吸取酸奶1ml
(2)制高层试管:将固体培养基加热、融化,冷却至50℃左右,用10ml移液管在每支无菌试管中灌9ml,然后放在45℃水浴中保温待用。
(3)梯度稀释:按常规方法用无菌移液管吸取1ml含菌试样至9ml半固体培养基试管中,然后使其充分均匀,然后吸1ml至下一支试管中,如此逐级稀释10-6为止
(4)恒温培养:待稀释均匀后,各稀释度的试管垂直放在试管架上,置37℃恒温培养24h左右
(5)观察与计数:经培养后,在高层半固体培养基试管内形成许多透镜状或近球状的菌落数出各试管中形成的菌落数目
(6)镜检:制片镜检观察
五、注意事项
(1)必须选用不含抗生素的牛奶作为发酵原料,否则将抑制乳酸菌的生长
(2)牛奶加热的温度如过高,会杀死酸奶中的乳酸菌造成发酵失败,如温度过低又会造成发酵缓慢,以摸着不烫手为度。
(3)在浇注平板法中,注入培养基不能太热,否则会烫死微生物
(4)挑取单菌落时应注意选取分散、孤立并具有典型特征的菌落,以尽快获得纯种
(5)乳酸菌计数时所用的稀释试管与菌落计数试管是同一试管,所以计数时应切记两点:一是因每管在混匀后都要吸出1ml,最后仅有的9ml培养基,所以长出的菌落数均应乘以10/9才能表示其实际菌落数。
二是最后稀释度试管中长出的菌落数,实为前一稀释度每毫升所含的菌落数,所以在乘稀释倍数时切忌出错。
六、实验结果
这是浓度从10-1-10-6LAB半固体培养基培养的乳酸菌
MRS固体培养基有淡白色的菌落产生,菌落较分散;MRS斜面有一层菌落覆盖,表面湿润,小而隆起乳酸杆菌菌体杆状,单个或成链,有时成丝状、产生假分枝。
六、实验分析
酸奶视觉质地:凝块状态、厚度、拉丝感一般、色泽洁白、表层光滑,无气泡和具有悦人香味,口腔触觉质地:爽滑,黏度与细腻度略差,风味:酸甜比不协调,甜度差,略有点苦,具有牛奶的自然香气,回味一般。
由于制作酸奶时没有考虑太多,就随便放了一点糖,由于糖放的少,让制作出来的酸奶口味不佳,我制备出来的酸奶,结果不是很令人满意,但我还是很喜欢,毕竟是我亲手制取出来的物品。
这种乳酸菌的计数方法虽然很简便快速,但是在这种稀释度下,我们在LAB半固体培养基培养出来的乳酸菌数量依然很大,在试管中无法准确地得出乳酸菌的数量,而且用LAB半固体培养基稀释时温度很难准确把握,刚移取前两个梯度的试管,后面几个梯度的试管就凝固啦,虽然是放在50℃的水浴锅中控制温度,依然会凝固,可能是配制LAB半固体培养基时,琼脂放多了导致这样的结果。
乳酸菌制片镜检,我们可以清楚看到乳酸杆菌菌体杆状,单个或成链,有时成丝状、产生假分枝。
此次实验制备乳酸奶的综合实验真是让我受益匪浅,我们首先要对实验有一个整体的认识,做到心里有数,在实验过程中,始终要树立无菌意识,以保证实验的顺利进行,还有做实验要思前想后,关键步骤要认真细心,可能一个小的环节出错,都会导致实验的失败,还有最重要的一点就是进一步学会与同学合作的精神,这样会让我们事半功倍,不但实验有收获,还能让我们心情愉悦。